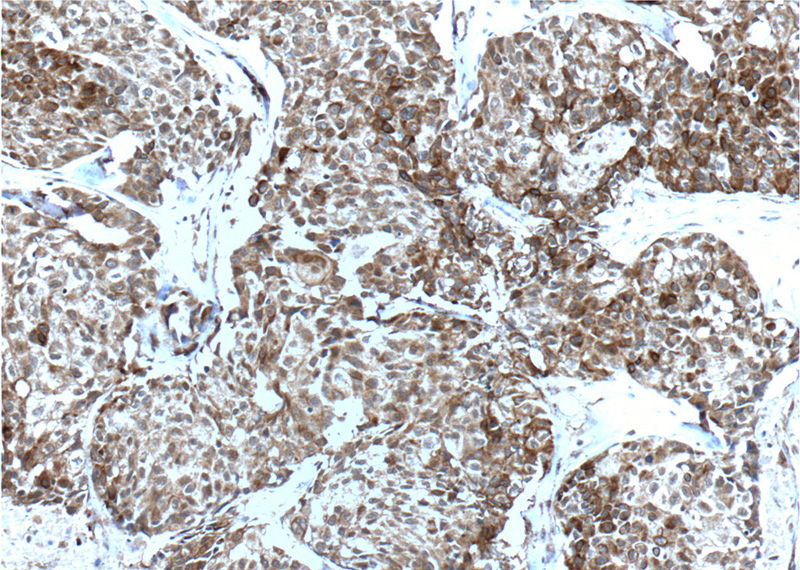
Immunohistochemistry of paraffin-embedded human lung cancer tissue slide using Catalog No:117105(Bcl-xL Antibody) at dilution of 1:200 (under 10x lens). heat mediated antigen retrieved with Tris-EDTA buffer(pH9).

-
Product Name
Bcl-XL antibody
- Documents
-
Description
Bcl-XL Rabbit Polyclonal antibody. Positive WB detected in C6 cells, A549 cells, human placenta tissue, Jurkat cells, K-562 cells, mouse placenta tissue, NIH/3T3 cells, Raji cells, RAW264.7 cells. Positive IP detected in K-562 cells. Positive IF detected in NIH/3T3 cells. Positive IHC detected in human lung cancer tissue, human colon cancer tissue. Positive FC detected in Jurkat cells. Observed molecular weight by Western-blot: 30-35 kDa
-
Tested applications
ELISA, IP, IF, WB, IHC, FC
-
Species reactivity
Human, Mouse; other species not tested.
-
Alternative names
Apoptosis regulator Bcl X antibody; BCL2L1 antibody; Bcl-XL antibody
- Immunogen
-
Isotype
Rabbit IgG
-
Preparation
This antibody was obtained by immunization of Bcl-XL recombinant protein (Accession Number: XM_011528964). Purification method: Antigen affinity purified.
-
Clonality
Polyclonal
-
Formulation
PBS with 0.1% sodium azide and 50% glycerol pH 7.3.
-
Storage instructions
Store at -20℃. DO NOT ALIQUOT
-
Applications
Recommended Dilution:
WB: 1:500-1:5000
IP: 1:200-1:2000
IHC: 1:50-1:500
IF: 1:10-1:100
-
Validations

C6 cells were subjected to SDS PAGE followed by western blot with Catalog No:117105(Bcl-xL Antibody) at dilution of 1:1000
Immunohistochemistry of paraffin-embedded human lung cancer tissue slide using Catalog No:117105(Bcl-xL Antibody) at dilution of 1:200 (under 10x lens). heat mediated antigen retrieved with Tris-EDTA buffer(pH9).

Immunohistochemistry of paraffin-embedded human lung cancer tissue slide using Catalog No:117105(Bcl-xL Antibody) at dilution of 1:200 (under 40x lens). heat mediated antigen retrieved with Tris-EDTA buffer(pH9).

Immunofluorescent analysis of NIH/3T3 cells using Catalog No:117105(Bcl-xL Antibody) at dilution of 1:25 and Rhodamine-Goat anti-Rabbit IgG

IP Result of anti-Bcl-xL (IP:Catalog No:117105, 3ug; Detection:Catalog No:117105 1:500) with K-562 cells lysate 8000ug.

1X10^6 Jurkat cells were stained with 0.2ug Bcl-xL antibody (Catalog No:117105, red) and control antibody (blue). Fixed with 4% PFA blocked with 3% BSA (30 min). Alexa Fluor 488-congugated AffiniPure Goat Anti-Rabbit IgG(H+L) with dilution 1:1500.
-
Background
BCL2L1 is a member of he BCL-2 protein family. BCL2L1 is expressed as two distinct isoforms, Bcl-xL and Bcl-xS, and is located at the outer mitochondrial membrane. The Bcl-XL isoform is a 233 amino acid protein, acting as an apoptotic inhibitor. Bcl-XL can forms heterodimers with BAX, BAK or BCL2, and the heterodimerization with BAX does not seem to be required for anti-apoptotic activity. The Bcl-XS isoform is a shorter variant that is 178 amino acids in length and lacks a 63 amino acid region (amino acids 126-188), acting as an apoptotic activator. This antibody can recognize Bcl-XL, Bcl-XS and Bcl-X(Beta).
-
References
- Lin C, Jiang X, Dai Z. Sclerostin mediates bone response to mechanical unloading through antagonizing Wnt/beta-catenin signaling. Journal of bone and mineral research : the official journal of the American Society for Bone and Mineral Research. 24(10):1651-61. 2009.
- Liu C, Gong K, Mao X, Li W. Tetrandrine induces apoptosis by activating reactive oxygen species and repressing Akt activity in human hepatocellular carcinoma. International journal of cancer. 129(6):1519-31. 2011.
- Gong K, Li W. Shikonin, a Chinese plant-derived naphthoquinone, induces apoptosis in hepatocellular carcinoma cells through reactive oxygen species: A potential new treatment for hepatocellular carcinoma. Free radical biology & medicine. 51(12):2259-71. 2011.
- Gong K, Xie J, Yi H, Li W. CS055 (Chidamide/HBI-8000), a novel histone deacetylase inhibitor, induces G1 arrest, ROS-dependent apoptosis and differentiation in human leukaemia cells. The Biochemical journal. 443(3):735-46. 2012.
- there was a problem with your PMID, try again.
- Li JJ, Gu QH, Li M, Yang HP, Cao LM, Hu CP. Role of Ku70 and Bax in epigallocatechin-3-gallate-induced apoptosis of A549 cells in vivo. Oncology letters. 5(1):101-106. 2013.
- Wei Y, Xu Y, Han X. Anti-cancer effects of dioscin on three kinds of human lung cancer cell lines through inducing DNA damage and activating mitochondrial signal pathway. Food and chemical toxicology : an international journal published for the British Industrial Biological Research Association. 59:118-28. 2013.
- Wan J, Liu T, Mei L. Synergistic antitumour activity of sorafenib in combination with tetrandrine is mediated by reactive oxygen species (ROS)/Akt signaling. British journal of cancer. 109(2):342-50. 2013.
Related Products / Services
Please note: All products are "FOR RESEARCH USE ONLY AND ARE NOT INTENDED FOR DIAGNOSTIC OR THERAPEUTIC USE"
